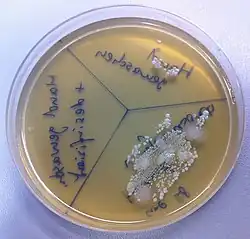

Händedesinfektion
In der Medizin versteht man unter Händedesinfektion ein Verfahren zur Verringerung der Zahl von Krankheitserregern auf der Haut der Hände mit Hilfe von Händedesinfektionsmitteln. Mit dieser Maßnahme der Basishygiene wird weitgehend vermieden, dass Krankheitserreger (insbesondere Bakterien und Viren) über die Hände auf andere Personen übertragen werden. In der Patientenversorgung wird mit diesem Verfahren das Ansteckungsrisiko gesenkt, insbesondere für Kreuzinfektionen; außerdem dient es dem eigenen Schutz der dort beschäftigten Personen.
Wirkung auf die Hautflora
Die Händedesinfektion ist die im Vergleich zum Händewaschen effektivere Maßnahme, um die mikrobielle Besiedelung – transiente und residente Hautflora – an den Händen auszuschalten bzw. zu reduzieren. Sie ist darüber hinaus hautschonender als eine Waschung.
Transiente Hautflora
Die transiente Hautflora besteht aus Keimen, die sich vorübergehend auf der Haut ansiedeln. Darunter können möglicherweise krankheitsverursachende (pathogene) Erreger sein. Durch Waschen der Hände wird die transiente Hautflora weitgehend entfernt, was aber in der Patientenversorgung als nicht ausreichend erachtet wird. Die fachgerechte Anwendung eines Händedesinfektionsmittels kann Erreger dagegen deaktivieren oder abtöten und bietet damit mehr Sicherheit vor einer Keimübertragung.
Residente Hautflora
Die residente Flora (Standortflora) ist Teil der physiologischen Beschaffenheit der Haut. Verschiedene darin enthaltene Mikroorganismen erhalten durch ihre Stoffwechselprodukte die normalen Hautfunktionen und hemmen das Wachstum nichtresidenter Keime. Doch können auch die Keime der residenten Hautflora Infektionen auslösen, beispielsweise auf nicht intakter Haut und im Körperinneren, wenn sie durch invasive Eingriffe eingebracht wurden. Daher muss auch die residente Hautflora vor bestimmten Tätigkeiten durch geeignete Desinfektionsverfahren reduziert werden.
Hygienische und chirurgische Händedesinfektion
Die hygienische Händedesinfektion wird vor und nach jedem Patientenkontakt durchgeführt, die gründlichere chirurgische Händedesinfektion dagegen vor Operationen oder invasiven Eingriffen. Die hygienische Händedesinfektion beseitigt die hautfremden Erreger und reduziert die Zahl der hauteigenen Erreger. Die chirurgische Händedesinfektion ist die weitgehende Eliminierung der hauteigenen Erreger, die in der Hornhaut bis zum Stratum lucidum in abnehmender Zahl vorhanden sind, wobei Schweiß- und Talgdrüsen normalerweise nahezu keimfrei sind.
Geschichtlicher Hintergrund
Den historisch entscheidenden Beitrag in der Medizin lieferte Ignaz Semmelweis (1818–1865), ein ungarisch-österreichischer Arzt. Er erkannte die Ursache für das Kindbettfieber und führte 1847 als erster Hygienevorschriften für Ärzte, Hebammen und Krankenhauspersonal ein. Zu seinen Vorschriften zählte auch die Anweisung, vor und nach jedem Patientenkontakt die Hände mit Chlorkalk zu desinfizieren. Er konnte damit die Anzahl der innerklinischen Todesfälle deutlich senken. Erst 1861 erschien sein Buch Die Ätiologie, der Begriff und die Prophylaxe des Kindbettfiebers. Die Unterscheidung zwischen hygienischer und chirurgischer Händedesinfektion wurde im Jahr 1905 von Carl Flügge eingeführt.[1]
Im Jahr 1888 verwendete Paul Fürbringer Alkoholsublimat zur Desinfektion der Hände vor Operationen. 1908 führte Antonio Grossich (1849–1926) die Desinfektion der Haut mit Jodtinktur vor Operationen ein.[2] Die Idee, statt der bisherigen Waschung der Hände mit unterschiedlichen Zusätzen ein Mittel zu entwickeln, das nur in die Hände eingerieben werden sollte, hatte 1965 Peter Kalmár, damals Assistenzarzt in der Chirurgischen Universitätsklinik Hamburg-Eppendorf. Damit sollte das Verfahren der Händedesinfektion effizienter, einfacher und schneller durchgeführt werden. Die Realisierung dieser Idee führte zur Entwicklung des alkoholischen Einreibeverfahrens zur hygienischen und chirurgischen Händedesinfektion. Kalmár war auch der Initiator der grundlegenden Änderung des Verfahrens der chirurgischen Händedesinfektion. Aufgrund der gesammelten Erfahrungen und des dermatologischen Kenntnisstandes setzte er sich intensiv für die heute allgemein akzeptierte Vorgehensweise ein, die damals übliche und zum Teil hautschädigende Vorwaschung mit Wasser, Seife und Bürste wegzulassen bzw. die gelegentlich erforderliche Handwaschung zeitlich vom Desinfektionsvorgang zu trennen.
Hygienische Händedesinfektion
Die hygienische Händedesinfektion ist die wichtigste Maßnahme zur Verhütung von Krankenhausinfektionen. Sie schützt den Patienten und das medizinische Personal. In vielen Krankenhäusern und Pflegeeinrichtungen können Besucher im Eingangsbereich oder auf den Stationen Händedesinfektionsgeräte nutzen, um zur Patientensicherheit beizutragen. Empfohlen wird außerdem, die Patienten über Händehygienemaßnahmen zu informieren und sie darin anzuleiten.[3]
Ignaz Semmelweis hatte seinerzeit Chlorkalk zur Händedesinfektion eingesetzt. Heute sollen zugelassene hautschonende Desinfektionsmittel verhindern, dass bei der Behandlung und Pflege von Patienten im Krankenhaus Infektionserreger übertragen und möglicherweise eine nosokomiale Infektion auslösen. Die üblichen Mittel wirken durch die Zerstörung der Einzeller-Hüllen. Gegen unbehüllte Viren sind spezielle Händedesinfektionsmittel nötig; z. B. muss bei Kontamination mit Hepatitis-B-Viren die Wirksamkeit des Mittels gegen diese Viren durch entsprechende Gutachten belegt sein. Bei Sporenbildnern (z. B. Clostridium difficile) müssen die Hände zusätzlich zur Desinfektion gewaschen werden.
Indikationen („Fünf-Momente-Konzept“)
Die Kommission für Krankenhaushygiene und Infektionsprävention (KRINKO) beschreibt in der aktuellen Empfehlung zur Händehygiene in Einrichtungen des Gesundheitswesens im sogenannten „Fünf-Momente-Konzept“ typische Situationen, in denen für Personal mit Patientenkontakt eine hygienische Händedesinfektion angebracht ist:
- vor Patientenkontakt
- vor aseptischen Tätigkeiten
- nach Kontakt mit potentiell infektiösen Materialien
- nach Patientenkontakt
- nach Kontakt mit Oberflächen in unmittelbarer Umgebung der Patienten.
Das „Fünf-Momente-Konzept“ entspricht dem My five Moments of Hand Hygiene-Modell der Weltgesundheitsorganisation (World Health Organization, WHO) und ersetzte mit der Veröffentlichung der Empfehlung zur Krankenhaushygiene im Jahr 2016 die vielzahligen Indikationen der KRINKO-Empfehlung in der Leitlinie aus dem Jahr 2000.[4]
Weitere maßgebliche Vorschriften stehen in den Unfallverhütungsvorschriften der Berufsgenossenschaften (§ 22, § 6 UVV). So nennt die Berufsgenossenschaft für Gesundheitsdienst und Wohlfahrtspflege (BGW) weitere Situationen, z. B.
- vor Arbeitsbeginn, beispielsweise in der ambulanten und stationären Pflege, in ärztlichen Praxen, in Küchen, im Operationsbereichen
- vor der Vorbereitung invasiver Maßnahmen und nach deren Nachbereitung
- vor jedem Umgang mit Lebensmitteln oder Medikamenten
- nach Toilettenbesuch
- nach Nutzung von Einmalhandschuhen.
Außerdem gelten die Vorschriften der jeweiligen Einrichtung.
Behandschuhte Hände dürfen laut KRINKO-Empfehlung nur in Ausnahmefällen während der Versorgung eines Patienten desinfiziert werden. Die dabei verwendeten Handschuhe müssen chemikalienbeständig gemäß EN 374 und dürfen nicht sichtbar perforiert sein sowie keine Kontamination mit Blut, Sekreten oder Ausscheidungen aufweisen.[5]
Voraussetzungen für eine effektive Händedesinfektion
Vor der Desinfektion müssen die Hände und Handgelenke frei von grobem Schmutz und ohne Schmuck- oder Eheringe, Armbanduhren, Armreife oder -bändern sein. Die Fingernägel sollten kurz geschnitten sein. Arm- und Fingerschmuck und lange sowie lackierte bzw. künstliche Fingernägel sind Nistplätze für Erreger und beeinträchtigen die Wirkung der Händedesinfektion. Sie sind daher bei Tätigkeiten, für die eine Händedesinfektion nötig ist, verboten.[6] Eine Ausnahme besteht aus Personalschutzgründen für das Tragen von Ringdosimetern, die aber nach jedem Gebrauch zu desinfizieren sind.[7] Außerdem empfehlen die WHO und die Kommission für Krankenhaushygiene und Infektionsprävention Arbeitskleidung mit kurzen Ärmeln für alle Berufsgruppen mit Patientenkontakt.[8]
Methode

Bei der Händedesinfektion mit einem alkoholischen Präparat wird mindestens die vom Hersteller angegebene Menge (meist ca. 2 bis 3 Hübe aus Wandspendern) in die trockene Hohlhand gegeben und auf beiden Händen innen und außen verrieben. Dabei sind Fingerspitzen, Daumen, Nagelfalze und Handgelenke mit einzubeziehen. Bei vermuteter Kontamination der Unterarme sind auch diese mit entsprechend angepasster Desinfektionsmittelmenge zu behandeln. Die Einwirkzeit ist vom Hersteller angegeben, sie beträgt in der Regel mindestens 30 Sekunden. Zur Inaktivierung bestimmter Erreger (z. B. Pseudomonas) ist eine längere Einwirkzeit nötig.[9]
Es gibt für die Händedesinfektion genaue Anleitungen, die eine bestimmte Reihenfolge der einzelnen Schritte vorsehen; nach DIN EN 1500: 1997-10 für die hygienische, nach DIN EN 12791: 2005-10 für die chirurgische Händedesinfektion. Es wurde jedoch nachgewiesen, dass individuelle Einreibemethoden zu besseren Ergebnissen führen.[10]
Chirurgische Händedesinfektion

Die chirurgische Händedesinfektion findet ihren Einsatz vor allen operativen Eingriffen. Ziel ist die weitgehende Erregerfreiheit durch Elimination der transienten und Reduktion der residenten Hautflora, um das Übertragungsrisiko bei einem möglichen Handschuhdefekt zu senken. Neben dem Operateur müssen sich alle im Sterilbereich arbeitenden Personen dieser Desinfektionsmaßnahme unterziehen.
Das vorangehende Waschen der Hände mit Wasser und Seife über eine Minute dient der Verminderung der Sporenlast. Es findet üblicherweise bei Betreten des Krankenhauses oder der Praxis statt. Ein Abbürsten der Haut bzw. der Fingernägel während der Waschung wird nur bei hartnäckigen Verschmutzungen empfohlen. Zur Schonung der Haut sollten zwischen Waschung und Verwendung des Desinfektionsmittels mindestens zehn Minuten vergehen,[11] da die lange Waschung die Hautfeuchtigkeit deutlich erhöht und die Wirkung des Desinfektionsmittels durch diesen Verdünnungseffekt herabsetzt.
Auf die sauberen und trockenen Hände kommt nur das Desinfektionsmittel. Durch die chirurgische Händedesinfektion mittels Einreiben alkoholischer Präparate über einen Zeitraum von bis zu fünf Minuten in die trockenen Hände und Unterarme wird die transiente Flora so stark reduziert, dass eine Keimweiterverbreitung bzw. Übertragung unterbunden wird. Dabei wird anfangs bis zum Ellbogen gearbeitet und am Schluss nur noch die Hände eingerieben. Vor dem Anziehen der Handschuhe müssen die Hände trocken sein. Die Dauer der Anwendung, d. h. der Benetzung der Hände mit dem Desinfektionsmittel, ist abhängig von der deklarierten Einwirkzeit des Herstellers.[12] Es stehen unterschiedliche Präparate mit Einwirkzeiten zwischen ein bis drei Minuten zur Verfügung (Stand Mai 2017).
Bei langen Operationen wird ein Wechsel der Handschuhe alle 90 Minuten ohne erneute Händedesinfektion empfohlen. Bei Operationen, die länger als drei Stunden dauern, ist im Zusammenhang mit dem Wechsel der Schutzkleidung eine erneute hygienische Händedesinfektion erforderlich, um die zwischenzeitlich aus den tieferen Schichten des Stratum corneum oder durch Kontamination an die Hautfläche gelangten Erreger abzutöten. Eine Händedesinfektion wird ebenfalls durchgeführt, wenn beschädigte OP-Handschuhe gegen intakte ausgetauscht werden.
Ursachen für fehlerhafte oder unterlassene Händedesinfektion
Die hygienische Händedesinfektion ist eine Standardmaßnahme zur Infektionsprophylaxe in der Patientenversorgung, die aber aus verschiedenen Gründen nicht häufig genug in wirksamer Weise umgesetzt wird. Zu den Faktoren, die die konsequente Umsetzung geeigneter Hygienemaßnahmen behindern, gehören unter anderen personelle Unterbesetzung, mangelnde Ausbildung und Erfahrung, mangelhafte Kenntnis der geltenden Empfehlungen und fehlende Motivation durch Vorgesetzte. Der Beruf des Arztes und Zugehörigkeit zum männlichen Geschlecht begünstigen ebenfalls eine unzureichende Händehygiene.[13]
Händedesinfektion im allgemeinen Alltagsleben
Händedesinfektionsmittel, die im medizinischen Bereich genutzt werden, sind im Haushalt nicht zu empfehlen, da sie auch unbedenkliche Keime abtöten, die der Körper braucht, um seine Abwehr zu trainieren. Das Waschen der Hände mit hautfreundlicher Seife reduziert die Keimmenge bis zu 99 %[14] und ist bei Verschmutzungen, nach dem Gang zur Toilette, nach dem Kontakt mit Türen oder Türklinken in öffentlichen Einrichtungen und nach dem Kontakt mit Tieren oder Menschen in der Regel eine ausreichende Hygienemaßnahme. Ausnahmen bestehen dann, wenn ein Familienmitglied krank ist oder unter einem geschwächten Immunsystem leidet.
Erfordernis der Hautpflege
Durch wiederholte Händedesinfektion wird die Haut angegriffen und vom Alkohol entfettet. Deshalb enthalten Händedesinfektionsmittel häufig rückfettende Komponenten. Zusätzliche Hautpflege wird empfohlen und ist in den Unfallverhütungsvorschriften genannt.
Siehe auch
Literatur, Medien
Zur chirurgischen Händedesinfektion
- Video Chirurgische Händedesinfektion ( vom 12. August 2007 im Internet Archive)
Zur hygienischen Händedesinfektion
- Informationen zur Händedesinfektion der Aktion Saubere Hände
- Th. Bernig: Vergleich der Hautverträglichkeit von sechs ausgewählten alkoholischen Händedesinfektionsmitteln im klinischen Doppelblindversuch anhand der subjektiven Akzeptanz und der Bestimmung objektiver Hautparameter. Diss Med Fak Univ Greifswald 1997.
- Klaus Koch: Kinderstube statt Logik. Hygiene-Verhalten der Ärzte untersucht. Süddt. Ztg., 3. April 2001, Deutschland S. V2/15.
Allgemein
- European Standard EN 1499: Chemische Desinfektionsmittel und Antiseptika, Desinfizierende Händewaschung, Prüfverfahren und Anforderungen (Phase 2/Stufe 2) 1998. Hygiene&Medizin 28. Jg. 2003, Heft 4; 129–133
- A. Kramer u. a. (Hrsg.): Klinische Antiseptik. Springer, Berlin 1993.
- Günter Kampf: Hände-Hygiene im Gesundheitswesen. Springer, Berlin 2004, ISBN 3-540-44200-6 (eingeschränkte Vorschau in der Google-Buchsuche).
- Kerstin Protz: Moderne Wundversorgung. Praxiswissen, Standards und Dokumentation, 10. Auflage, Elsevier, München 2023, ISBN 978-3-437-27887-7
Weblinks
- Empfehlung der KRINKO, veröffentlicht im Bundesgesundheitsblatt, 2016 (PDF) (aufgerufen am 11. Dezember 2024).
- S2k-Leitlinie Händedesinfektion und Händehygiene, Leitlinie der Deutschen Gesellschaft für Krankenhaushygiene (federführend), herausgegeben von der Arbeitsgemeinschaft der Wissenschaftlichen Medizinischen Fachgesellschaften, AWMF-Leitlininregister-Nummer 075-004, Stand Februar 2023, gültig bis Februar 2028.
- Aktion Saubere Hände: Videotutorial für medizinisches Personal in Krankenhäusern, abgerufen am 1. September 2014.
- Fachrichtlinie Hygienische Händedesinfektion des Institutes für Krankenhaushygiene und Mikrobiologie, 2022
Einzelnachweise
- ↑ R. H. Steinhagen: Entwicklungsstadien der Händedesinfektion. In: Eckert/Rodewald: Hygiene und Asepsis in der Chirurgie, S. 55–61, hier: S. 57. Vgl. auch: Sonderdruck aus: Volker Schumpelick, Niels M. Bleese, Ulrich Mommsen (Hrsg.): Chirurgie. Lehrbuch für Studenten. Stuttgart o. J., S. 51.
- ↑ Paul Diepgen, Heinz Goerke: Aschoff/Diepgen/Goerke: Kurze Übersichtstabelle zur Geschichte der Medizin. 7., neubearbeitete Auflage. Springer, Berlin/Göttingen/Heidelberg 1960, S. 51 und 59.
- ↑ Musterpräsentation zur KRINKO Empfehlung (2016) Händehygiene. S. 18; abgerufen am 3. März 2019.
- ↑ S. Niknam: Neue KRINKO-Empfehlung Händehygiene: Jeder Moment zählt. In: Heilberufe, 2017, Heft 2, Jahrgang 68, S. 28–31.
- ↑ Musterpräsentation zur KRINKO Empfehlung (2016) Händehygiene. S. 34–35; abgerufen am 3. März 2019.
- ↑ Empfehlungen der Kommission für Krankenhaushygiene und Infektionsprävention (KRINKO) am Robert Koch-Institut. Abgerufen am 3. März 2019.
- ↑ Musterpräsentation zur KRINKO Empfehlung (2016) Händehygiene, S. 9; abgerufen am 13. März 2019.
- ↑ Klinikkonzern mustert Langarmkittel für Ärzte aus. kma Online vom 1. Februar 2016; abgerufen am 7. März 2019.
- ↑ "Händehygiene: Ein zentraler Baustein der Hygiene im Betrieb ist die Händehygiene", Informationen der Berufsgenossenschaft für Gesundheitsdienst und Wohlfahrtspflege, auf der Website der BGW; abgerufen am 11. Dezember 2024.
- ↑ M. Dülligen, A. Kirov, H. Unverricht: Hygiene und medizinische Mikrobiologie. Schattauer, Stuttgart 2013; S. 206
- ↑ S2k-Leitlinie Händedesinfektion und Händehygiene, Leitlinie der Deutschen Gesellschaft für Krankenhaushygiene (federführend), herausgegeben von der Arbeitsgemeinschaft der Wissenschaftlichen Medizinischen Fachgesellschaften, AWMF-Leitlininregister-Nummer 075-004, Stand Februar 2023, gültig bis Februar 2028, abgerufen am 11. Dezember 2023
- ↑ Vorgaben des Bundesgesundheitsblattes 2016.
- ↑ Epidemiologisches Bulletin Nr. 5, Robert-Koch-Institut 2005, S. 36; abgerufen am 3. März 2019.
- ↑ Hygiene-Tipps für Kids. Informationen zur Händeyhgiene. (PDF) In: Institut für Hygiene und Öffentliche Gesundheit der Universität Bonn. 1. März 2015, archiviert vom (nicht mehr online verfügbar) am 22. Februar 2019; abgerufen am 15. Mai 2020.